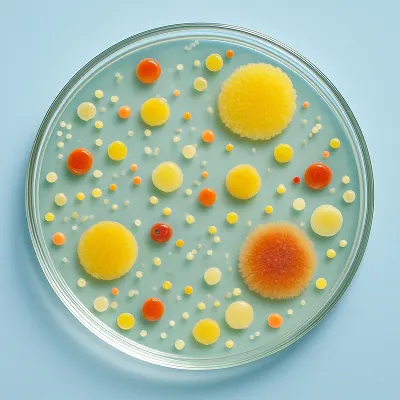
Оценка биологической нагрузки - исследуем популяции микроорганизмов, присутствующих на продукции, предназначенной для стерилизации

Испытательная лаборатория Инвитро
Реализуем качественные лабораторные исследования благодаря профессиональной команде, современному оборудованию и отлаженным технологическим процессам по следующим направлениям:
Производственный контроль в медицинских организациях
Определение бионагрузки и стерильности для изделий медицинского назначения
Аккредитованная лаборатория Инвитро
Испытательная лаборатория отдела санитарной бактериологии Инвитро имеет государственную аккредитацию в Национальной системе аккредитации испытательных лабораторий на проведение лабораторно-инструментальных исследований
Смотреть сертификат и область аккредитации на сайте ФГИС
Федеральная государственная информационная система

Программа производственного контроля
Проводим исследования в медицинских организациях с целью профилактики инфекционных заболеваний и внутрибольничных инфекций
Мы предлагаем:
Оценка соблюдения дезинфекционного режима
Контроль стерильности изделий медицинского назначения
Оценка эффективности работы стерилизующего оборудования
Контроль воздушной среды в помещениях
Испытания в области промышленной бактериологии
Проводим оценку популяции микроорганизмов на изделиях медицинского назначения для определения бионагрузки и стерильности по ГОСТ 11737*. Обеспечиваем надежное подтверждение безопасности и соответствия продукции действующим стандартам
*ГОСТ ИСО 11737-1-2022 «Стерилизация медицинской продукции. Микробиологические методы. Часть 1: Определение популяции микроорганизмов на изделиях» и ГОСТ ИСО 11737-2-2022 «Стерилизация медицинской продукции. Микробиологические методы. Часть 2. Исследования на стерильность, выполняемые при определении, валидации и техническом обслуживании процесса стерилизации
Мы предлагаем:
Оценка биологической нагрузки — исследуем популяции микроорганизмов, присутствующих на продукции, предназначенной для стерилизации

Оценка стерильности — испытываем изделия медицинского назначения на наличие/отсутствие жизнеспособных микроорганизмов
Преимущества Инвитро:
Экспертиза
Собственная аккредитованная лаборатория с современным оборудованием и сертифицированным персоналом
1
Персональный подход
- Персональный менеджер - окажем помощь на всех этапах сопровождения заказа: от заявки до получения протокола и по широкому профилю вопросов, включая вопросы соблюдения санитарного законодательства
- Выезд без остановки работы клиники - подстроимся под ваш график
- Отправим оригинал протокола исследований курьером в удобную точку
2
Выгода
- Оплата только за нужные вам исследования по факту оказания услуг
- Конкурентные цены
3
Гарантия сроков
Регламентированные сроки выполнения исследований (от 3 до 14 дней в зависимости от вида исследований)
4
Результат
- Официальный протокол с результатами, помощь в подготовке к повторным испытаниям при необходимости
- Рекомендации по устранению нарушений
5
Нам доверяют
Мы работаем с клиентами по всей стране: проводим производственный контроль в Москве и Московской области, а также предоставляем решения по оценке бионагрузки и стерильности по всей России





Получите персональную консультацию по своему запросу
Оставьте заявку на обратный звонок
Остались вопросы?
Напишите нам на почту